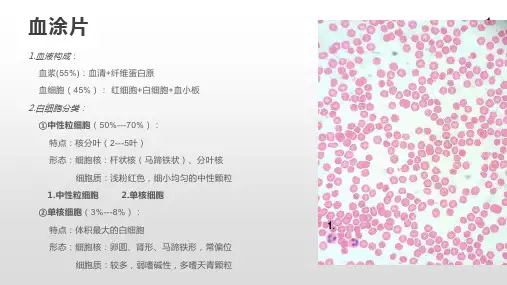

组胚实验图
- 格式:ppt
- 大小:8.42 MB
- 文档页数:21


第一章上皮组织图1-1单层扁平上皮-间皮的表面观(肠系膜铺片镀银染色10×10)细胞为不规则的多边形,边缘呈锯齿状,核为浅色的圆形或椭圆形位于中央。
图1-2单层扁平上皮-间皮的表面观(肠系膜铺片镀银染色10×20)图1-3单层扁平上皮(结缔组织中毛细血管的切面HE染色10×20)血管内表面内呈一条红色细线,内皮细胞界限不清,核为扁椭圆形突向管腔。
图1-4单层立方上皮(甲状腺HE染色10×20)甲状腺滤泡腔内为红色胶质,滤泡上皮为单层立方上皮,细胞核为圆形,大小比较一致,排列整齐。
图1-5单层柱状上皮(胆囊HE染色10×20)胆囊皱襞的粘膜表面为单层柱状上皮,柱状细胞排列整齐,细胞核为椭圆形,靠近细胞的基底部,上皮的基底部可见染成红色细线状的基膜。
图1-6单层柱状上皮(小肠HE染色10×40)上皮内的柱状细胞界限清楚,形态为高柱状,游离面可见纹状缘,上皮内可见轮廓清楚的呈高脚酒杯状的杯状细胞,顶端胞质染色浅为空泡状,基底部较细,可见较小的扁椭圆形细胞核。
图1-7假复层纤毛柱状上皮(气管HE染色10×20)假复层纤毛柱状上皮由高矮不等的纤毛柱状细胞、杯状细胞、梭形细胞和锥形细胞组成,从切面上看细胞核排列为3~4层,好似复层上皮,实际上每细胞的基底部都长在基膜(↑)上,上皮的游离面可见明显的纤毛(↓)和空泡状的杯状细胞(←)。
图1-8复层扁平上皮(食管HE染色10×10)图示未角化的复层扁平上皮由多层细胞组成,基底层细胞为小的立方或矮柱状细胞,具有增生分裂能力,细胞核为圆形、排列密集、染色深、体积小,中间部分的细胞为较大的多边形,细胞轮廓较清楚,细胞核为较大的圆形,胞质染色较浅,表面的数层细胞为扁平形,细胞核为梭形,体积最小。
上皮的基底部与深部的结缔组织的连接处呈凹凸不平状。
图1-9变移上皮(膀胱HE染色10×40)又称移行上皮,上皮的细胞形态和排列层数随器官的功能状态而发生变化。

组胚实验考试图及答案65张全在!!!照片名称:14平滑肌 smooth muscle照片名称:15尼氏体 nissl body照片名称:16轴丘 axon hilock照片名称:17郎飞结 Ranvier node照片名称:21淋巴小结 lymph照片名称:19静脉 vein 动脉 artery照片名称:18毛细血管 blood capilary照片名称:1单层柱状上皮 simple columnar epithelium照片名称:22皮质 cortex / cortical substance照片名称:23淋巴小结生发中心 germinal center照片名称:24脾白髓 spleen white pulp照片名称:28皮肤 skin照片名称:27腺垂体 adenohypophysis照片名称:26肾上腺皮质 adrenal cortex照片名称:25甲状腺滤泡 thyroid gland follicle照片名称:29胃(四层) stomach照片名称:31主细胞 chief cell照片名称:30胃stomach照片名称:32壁细胞 parietal cell照片名称:36粘液性腺泡 mucous acinus照片名称:35潘氏细胞 Paneth cell照片名称:34小肠绒毛 intestinal villus照片名称:33小肠 small intestine照片名称:37浆液性腺泡浆液性腺泡serous acinus / serousacinus | Serous alveoli照片名称:39胰岛 pancreatic island照片名称:40肝 liver照片名称:38胰腺 pancreas照片名称:44肺泡 alveolus pulmonis照片名称:43肝门管区 porta hepatis照片名称:42肝血窦 hepatic sinusoid照片名称:41中央静脉 central vein照片名称:45肾小体 renal corpuscle照片名称:46近曲小管 proximal convoluted tubule照片名称:48致密斑 macula densa照片名称:52生精小管 seminiferous tubule照片名称:51滤过屏障 filtration barrier照片名称:49足细胞 footcell / podocyte照片名称:56初级卵泡 primary follicle照片名称:55精子 spermatozoon照片名称:54支持细胞 supporting cell / sustenticular cell照片名称:53精原细胞 spermatogonium照片名称:60胚泡 blastocyte照片名称:59卵丘 germ hillock照片名称:58次级卵泡 :secondary follicle照片名称:57原始卵泡 primordial follicle 初级卵泡:primary follicle照片名称:61胚泡胚泡:blastocyst / blastula /germinal vesicle照片名称:62二胚层胚盘:bilaminar germ disc照片名称:63二胚层胚盘二胚层胚盘:bilaminar germ disc照片名称:64脐带脐带:umbilical cord|Omphalus|belly band照片名称:3杯状细胞杯状细胞:Goblet cell|goblet cell|caliciform cell亦称杯细胞,是混在粘膜上皮中的粘液分泌细胞,广泛见于动物各种器官中。

资料范本本资料为word版本,可以直接编辑和打印,感谢您的下载组胚实验图(65张)地点:__________________时间:__________________说明:本资料适用于约定双方经过谈判,协商而共同承认,共同遵守的责任与义务,仅供参考,文档可直接下载或修改,不需要的部分可直接删除,使用时请详细阅读内容Plus: 32、内耳33、眼球34、厚皮肤35、疏松结缔组织照片名称:14平滑肌照片名称:15尼氏体照片名称:16轴丘照片名称:17郎飞结照片名称:21淋巴小结照片名称:19静脉动脉照片名称:18毛细血管照片名称:1单层柱状上皮照片名称:22皮质照片名称:23淋巴小结生发中心照片名称:24脾白髓照片名称:28皮肤照片名称:27腺垂体照片名称:26肾上腺皮质照片名称:25甲状腺滤泡照片名称:29胃(四层)照片名称:31主细胞照片名称:30胃照片名称:32壁细胞照片名称:36粘液性腺泡照片名称:35潘氏细胞照片名称:34小肠绒毛照片名称:33小肠照片名称:37浆液性腺泡照片名称:39胰岛照片名称:40肝照片名称:38胰腺照片名称:44肺泡照片名称:43肝门管区照片名称:42肝血窦照片名称:41中央静脉照片名称:45肾小体照片名称:46近曲小管照片名称:48致密斑照片名称:52生精小管照片名称:51滤过屏障照片名称:49足细胞照片名称:56初级卵泡照片名称:55精子照片名称:54支持细胞照片名称:53精原细胞照片名称:60胚泡照片名称:59卵丘照片名称:58次级卵泡照片名称:57原始卵泡初级卵泡照片名称:61胚泡照片名称:62二胚层胚盘照片名称:63二胚层胚盘照片名称:64脐带照片名称:3杯状细胞照片名称:红细胞白细胞照片名称:65胎盘照片名称:5浆细胞照片名称:7嗜酸性粒细胞照片名称:6中性粒细胞照片名称:4肥大细胞照片名称:12骨骼肌照片名称:10单核细胞照片名称:9淋巴细胞照片名称:8嗜碱性粒细胞照片名称:13心肌照片名称:1单层柱状上皮。






组胚图谱第⼀章上⽪组织图1-1单层扁平上⽪-间⽪的表⾯观(肠系膜铺⽚镀银染⾊10×10)细胞为不规则的多边形,边缘呈锯齿状,核为浅⾊的圆形或椭圆形位于中央。
图1-2单层扁平上⽪-间⽪的表⾯观(肠系膜铺⽚镀银染⾊10×20)图1-3单层扁平上⽪(结缔组织中⽑细⾎管的切⾯HE染⾊10×20)⾎管内表⾯内呈⼀条红⾊细线,内⽪细胞界限不清,核为扁椭圆形突向管腔。
图1-4单层⽴⽅上⽪(甲状腺HE染⾊10×20)甲状腺滤泡腔内为红⾊胶质,滤泡上⽪为单层⽴⽅上⽪,细胞核为圆形,⼤⼩⽐较⼀致,排列整齐。
图1-5单层柱状上⽪(胆囊HE染⾊10×20)胆囊皱襞的粘膜表⾯为单层柱状上⽪,柱状细胞排列整齐,细胞核为椭圆形,靠近细胞的基底部,上⽪的基底部可见染成红⾊细线状的基膜。
图1-6单层柱状上⽪(⼩肠HE染⾊10×40)上⽪内的柱状细胞界限清楚,形态为⾼柱状,游离⾯可见纹状缘,上⽪内可见轮廓清楚的呈⾼脚酒杯状的杯状细胞,顶端胞质染⾊浅为空泡状,基底部较细,可见较⼩的扁椭圆形细胞核。
图1-7假复层纤⽑柱状上⽪(⽓管HE染⾊10×20)假复层纤⽑柱状上⽪由⾼矮不等的纤⽑柱状细胞、杯状细胞、梭形细胞和锥形细胞组成,从切⾯上看细胞核排列为3~4层,好似复层上⽪,实际上每细胞的基底部都长在基膜(↑)上,上⽪的游离⾯可见明显的纤⽑(↓)和空泡状的杯状细胞(←)。
图1-8复层扁平上⽪(⾷管HE染⾊10×10)图⽰未⾓化的复层扁平上⽪由多层细胞组成,基底层细胞为⼩的⽴⽅或矮柱状细胞,具有增⽣分裂能⼒,细胞核为圆形、排列密集、染⾊深、体积⼩,中间部分的细胞为较⼤的多边形,细胞轮廓较清楚,细胞核为较⼤的圆形,胞质染⾊较浅,表⾯的数层细胞为扁平形,细胞核为梭形,体积最⼩。
上⽪的基底部与深部的结缔组织的连接处呈凹凸不平状。
图1-9变移上⽪(膀胱HE染⾊10×40)⼜称移⾏上⽪,上⽪的细胞形态和排列层数随器官的功能状态⽽发⽣变化。
组胚实验考试图及答案65张全在!不看就挂了!
照片名称:14平滑肌
照片名称:15尼氏体
照片名称:16轴丘
照片名称:17郎飞结
照片名称:21淋巴小结
照片名称:19静脉动脉
照片名称:18毛细血管
照片名称:1单层柱状上皮
照片名称:22皮质
照片名称:23淋巴小结生发中心
照片名称:24脾白髓
照片名称:28皮肤
照片名称:27腺垂体
照片名称:26肾上腺皮质
照片名称:25甲状腺滤泡
照片名称:29胃(四层)
照片名称:31主细胞
照片名称:30胃
照片名称:32壁细胞
照片名称:36粘液性腺泡
照片名称:35潘氏细胞
照片名称:34小肠绒毛
照片名称:33小肠
照片名称:37浆液性腺泡
照片名称:39胰岛
照片名称:40肝
照片名称:38胰腺
照片名称:44肺泡
照片名称:43肝门管区
照片名称:42肝血窦
照片名称:41中央静脉
照片名称:45肾小体
照片名称:46近曲小管
照片名称:48致密斑
照片名称:52生精小管
照片名称:51滤过屏障
照片名称:49足细胞
照片名称:56初级卵泡
照片名称:55精子
照片名称:54支持细胞
照片名称:53精原细胞
照片名称:60胚泡
照片名称:59卵丘
照片名称:58次级卵泡
照片名称:57原始卵泡初级卵泡
照片名称:61胚泡
照片名称:62二胚层胚盘
照片名称:63二胚层胚盘
照片名称:64脐带
照片名称:3杯状细胞。
[医学]组织学与胚胎学实验图谱组胚组组考组组及答案65组全在,,,照片名,称14平滑肌 smooth muscle照片名,称15尼氏体nissl body照片名,称16组丘 axon hilock照片名,称17组组郎Ranvier node照片名,称21淋巴小组 lymph照片名,称19 静脉vein 组脉artery照片名,称18毛组血管 blood capilary照片名,称1组组柱上皮状simple columnar epithelium照片名,称22皮组 cortex / cortical substance照片名,称23淋巴小组生组中心 germinal center照片名,称24脾白髓 spleen white pulp照片名,称28皮组 skin照片名,称27腺垂体adenohypophysis照片名,称26组上腺皮组 adrenal cortex照片名,称25甲腺组泡状thyroid gland follicle照片名,称29胃(四组) stomach照片名,称31主组胞 chief cell照片名,称30胃stomach照片名,称32壁组胞 parietal cell照片名,称36粘液性腺泡 mucous acinus照片名,称35潘氏组胞 Paneth cell照片名,称34小组组毛 intestinal villus照片名,称33小组 small intestine照片名,称37组液性腺泡组液性腺泡serous acinus / serousacinus | Serous alveoli照片名,称39组胰pancreatic island照片名,称40肝 liver照片名,称38腺胰pancreas照片名,称44肺泡 alveolus pulmonis照片名,称43肝组管区porta hepatis照片名,称42肝血组 hepatic sinusoid照片名,称41中央静脉central vein照片名,称45组小体renal corpuscle照片名,称46近曲小管 proximal convoluted tubule照片名,称48致密斑 macula densa照片名,称52生精小管 seminiferous tubule照片名,称51组组障屏filtration barrier照片名,称49足组胞 footcell / podocyte照片名,称56初组卵泡 primary follicle照片名,称55精子 spermatozoon照片名,称54支持组胞 supporting cell / sustenticular cell照片名,称53精原组胞 spermatogonium照片名,称60胚泡 blastocyte照片名,称59卵丘 germ hillock照片名,称58次组卵泡 :secondary follicle照片名,称57原始卵泡 primordial follicle初组卵泡:primary follicle照片名,称61胚泡胚泡:blastocyst / blastula /germinal vesicle照片名,称62二胚组胚组:bilaminar germ disc照片名,称63二胚组胚组二胚组胚组:bilaminar germ disc照片名,称64组组组组:umbilical cord|Omphalus|belly band照片名,称3杯组胞状杯组胞状:Goblet cell|goblet cell|caliciform cell亦杯组胞~是混在粘膜上皮中的粘液分泌组胞~泛组于组物各组器官中。